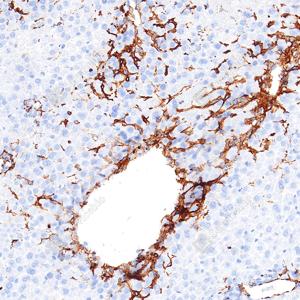

Recombinant Anti-alpha smooth muscle Actin antibody (Rabbit mAb)
- 100 μL
产品信息
蛋白质全称 | 主动脉平滑肌肌动蛋白 |
别名 | Actin, aortic smooth muscle, Alpha-actin-2, Cell growth-inhibiting gene 46 protein, ACTA2, ACTSA, ACTVS, GIG46, SMA, a-sma, sma |
Uniprot ID | P62736 |
免疫原 | KLH偶联的人alpha smooth muscle actin合成肽 |
抗体亚型 | IgG |
克隆号 | SB554 |
预测分子量./观测分子量. | 42 kDa / 42 kDa |
纯化方式 | 亲和纯化 |
亚细胞定位 | 细胞质 |
应用
| 应用 | 物种 | 稀释 | 阳性样品 |
| IHC/IF 免疫组织化学/免疫荧光 | 人, 小鼠, 大鼠 | 1: 1000-1: 2000 | 纤维性肝, 纤维性肺 |
背景
Alpha-actin-2 also known as actin, aortic smooth muscle or alpha smooth muscle actin (α-SMA, SMactin, alpha-SM-actin, ASMA). Actin alpha 2, the human aortic smooth muscle actin gene, is one of six different actin isoforms which have been identified. Actins are highly conserved proteins that are involved in cell motility, structure and integrity. Alpha actins are a major constituent of the contractile apparatus.Alpha-smooth muscle actin (α-SMA) is commonly used as a marker of myofibroblast formation.
图像
| IHC检测alpha smooth muscle Actin蛋白(货号 YB15055). 样品: 小鼠纤维性肝, 4%多聚甲醛 (货号Y1112) 固定12-24小时. 抗原修复: 抗原修复仪 (货号 YRI-4),Tris-EDTA抗原修复液(pH 9.0) (货号Y1214), 水浴100℃, 25分钟. —抗: 1: 2000稀释, 4℃ 孵育过夜. 二抗: S-vision免疫组化多聚二抗(山羊抗兔),即用型 (货号Y1313), 室温孵育20分钟. |
| IHC检测alpha smooth muscle Actin蛋白(货号 YB15055). 样品: 大鼠纤维性肝, 4%多聚甲醛 (货号Y1112) 固定12-24小时. 抗原修复: 抗原修复仪 (货号 YRI-4),Tris-EDTA抗原修复液(pH 9.0) (货号Y1214), 水浴100℃, 25分钟. —抗: 1: 2000稀释, 4℃ 孵育过夜. 二抗: S-vision免疫组化多聚二抗(山羊抗兔),即用型 (货号Y1313), 室温孵育20分钟. |
| IHC检测alpha smooth muscle Actin蛋白(货号 YB15055). 样品: 大鼠纤维化肺, 4%多聚甲醛 (货号Y1112) 固定12-24小时. 抗原修复: 抗原修复仪 (货号 YRI-4),Tris-EDTA抗原修复液(pH 9.0) (货号Y1214), 水浴100℃, 25分钟. —抗: 1: 2000稀释, 4℃ 孵育过夜. 二抗: S-vision免疫组化多聚二抗(山羊抗兔),即用型 (货号Y1313), 室温孵育20分钟. |
储存
| 储存条件 | 在-20℃下储存一年, 避免反复冻融. |
| 储存缓冲液 | 含0.15% ProClin300防腐剂, 100 μg/mL牛血清白蛋白和50%甘油的磷酸盐缓冲液. |
注意:
1.本产品仅供研究使用.
2.建议用一抗稀释液(Y2036)稀释本产品.
| 货号 | 名称 | 规格 | 价格 | 操作 |
|---|
| 货号 | 名称 | 规格 | 价格 | 操作 |
|---|